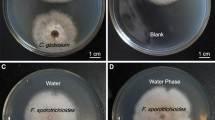

Abstract
Wilt disease caused by Fusarium solani, a soil-borne plant pathogenic fungus, is a serious disease in tomato causing economic losses. In the present study, among the nine isolates of Chaetomium globosum Kunze (Chg1–Chg9), screened against F. solani No. Fs-1, Chg2 exhibited the maximum inhibition (49.2 %), followed by the isolates Chg6 (47.4%) and Chg1 (46.3%) in dual culture. Further, the crude secondary metabolites from these three isolates showed maximum reduction of the mycelial growth of Fs-1 compared to control. Gas Chromatography-Mass Spectrometry (GC-MS) analysis of the metabolites from Chg2 revealed the presence of major compounds, viz., benzothiazole, 2-(2-hydroxyethylthio) (7.51%); 9,12,15- octadecatrienoic acid, 2,3-bis[(trimethylsilyl)oxy] propyl ester (3.13%); and hexadecanoic acid, 1- (hydroxymethyl)-1,2-ethanediyl ester (2.69%). Fourier transform infrared (FTIR) spectroscopy revealed the presence of alcohol, secondary amine, aliphatic primary amine, carboxylic acid, allene, conjugated ketone, imine/oxime, sulphate, and halo compound groups with a weak to strong range of intensity. Pure compound of benzothiazole @ 5000 ppm exhibited higher antagonistic activity of Fs-1which decreased at lower concentration. In pot culture experiment, dipping tomato seedlings cv. PKM1 in 2% ethyl acetate–fractionated biomolecules of Chg2 recorded a minimum disease incidence of 20.0%, whereas seedlings dipped in the culture filtrate of Chg2 showed a disease incidence of 26.6% compared to control (86.6%). Besides, these seedlings treated with the culture filtrate showed the highest plant height of 37.68 cm and the maximum number of leaves and flowers (39.6 and 5.48, respectively), followed by those treated with the biomolecules of Chg2 (C. globosum) and the culture filtrate of T. asperellum. The results revealed that the antifungal efficacy of C. globosum Chg2 is due to the presence of antimicrobial metabolites including benzothiazole. Exploring the use of this novel antifungal compound in the management of plant diseases is highly warranted.
Similar content being viewed by others
Avoid common mistakes on your manuscript.
Introduction
Tomato (Family: Solanaceae) is one of the world’s most important vegetable crops used for vegetable and culinary purpose. The productivity of the crop has declined due to the infection of various soil-borne plant pathogens. Among the diseases, wilt and root rot diseases significantly affect the growth and yield in tomato. Wilt is a severe soil-borne disease of tomato caused by the fungi Fusarium solani and Verticillium [11]. Among these, F. solani cause 30–40% yield losses in India, which can reach up to 80% during favorable weather conditions. The typical symptoms of the disease include necrotic lesions, vascular discoloration, and yellowing of leaves that begin with older leaves.
The pathogen can survive in soil for long period of time as chlamydospores. It colonizes the host and non-host tissues and successfully competes with other soil fungi. The pathogen can occur at high population levels in surface soil near diseased plants, presumably from macroconidia produced on stem lesions. The macroconidia cells are transformed into resting chlamydospores. Generally, seed acts as a primary source of inoculum, where the fungus is deeply seated in the seed coat in the form of chlamydospores. The infected seeds show a transmission rate of 2–16% infection. The pathogen invades the root epidermis and extends into the vascular tissue. It colonizes the xylem vessels producing mycelium and conidia. The characteristic wilt symptom appears as a result of severe water stress, mainly due to clogging of vascular vessels [29].
Conventional methods using chemicals is usually practiced by the farmers which is not long lasting and does not provide complete protection to the crop. Besides, lack of reliable chemicals, fungicidal resistance, and circumvention of host resistance by plant pathogen populations are some of the critical constraints underlying the efforts to develop fungal bioagents for crop disease management. Moreover, an increase in the awareness of green cultivation and organic farming warrants alternative ecofriendly strategies for the management of tomato wilt. Biological control is one of the most attractive and accepted methods for controlling soil-borne plant diseases. Controlling Fusarium wilt with antagonistic microorganisms represents an alternative disease management strategy because of its ability to provide benign disease control [20].
The mechanisms by which biocontrol agents suppress pathogens include antibiosis, competition, growth promotion, and induction of resistance in plants. Besides, many fungal bioagents produce secondary metabolites and some of these compounds exhibit antifungal and antibacterial activities that strongly inhibit the growth of other microorganisms [21]. For instance, several species of Chaetomium act as potential bioagents of plant pathogenic fungi. Chaetomium is a fungal biocontrol agent belonging to the phylum Ascomycota, class Sordariomycetes, and family Chaetomiaceae, which contains more than 250 species. It is characterized by dark perithecia with a short neck, which are covered with unevenly coiled or tightly spiralled hairs or with stiff, simple, or branched setae [14, 31]. Several species of Chaetomium inhibit the growth of fungi and bacteria through competition, mycoparasitism, antibiosis, lysis, or various combinations of these mechanisms [27, 32, 34]. Chaetomium spp. have also been reported to be potentially antagonistic to seed and soil-borne plant pathogens [2, 3]. In particular, Chaetomium globosum and Chaetomium cupreum have been extensively studied and successfully used to control leaf spot disease of corn caused by Curvularia lunata, rice blast caused by Pyricularia oryzae, sheath blight caused by Rhizoctonia solani, and late blight disease of potato caused by Phytophthora infestans [27, 30]. These two species have also been shown to inhibit tomato wilt caused by F. solani [28, 32]. The mycotoxin chaetoglobosin C isolated from Chaetomium globosum used for the management of Fusarium–Meloidogyne wilt complex in tomato [23]. Accordingly, we have isolated Chaetomium spp. from different ecosystem and exploring it against various plant pathogens. The main aim of this study is to identify and characterize the antimicrobial metabolites from Chaetomium globosum and utilize it for the management of F. solani in tomato.
Material and Methods
Isolation and Identification of Fusarium sp.
Infected tissues from the collar and root region of tomato plants showing wilt symptoms were collected from a farmer’s field in Annur, Coimbatore district, Tamil Nadu, India. By using the tissue segment method, the pathogen was isolated on the potato dextrose agar (PDA) medium. Small pieces of tissues were cut from the collar region, surface sterilized with 10,000 ppm sodium hypochlorite for 1 min, washed in sterile distilled water three times, and dried on a sterilized filter paper. Then, the pieces were placed in Petri plates containing PDA medium and incubated at 28°C ± 2°C for 7 days. The pure culture of the fungus was obtained using the single hyphal tip method [24].
Morphological Characterization of the Pathogen
The pathogen was identified at the genus level based on the cultural and morphological characteristics of the fungus. Cultural characters of the pathogen, viz., colour, shape, texture of the fungal colony, formation of fruiting bodies, growth rate, and sporulation, were identified [25]. To study the morphological characters, a piece of mycelium was placed on a glass slide, and mycelial colour, septation, and asexual spores (conidia) were observed under a stereomicroscope (Labomed, USA).
Molecular Identification of the Pathogen
The isolated pathogen was identified at the species level by extracting DNA from a 7-day-old culture of Fusarium sp. grown in potato dextrose broth by using the cetyl trimethyl ammonium bromide (CTAB) method [10, 18]. The mycelial mat of Fusarium sp. was ground to a fine powder with liquid nitrogen in a precooled pestle and mortar. The mycelial powder was transferred to a 2-mL Eppendorf tube containing 750 μL of preheated CTAB buffer (100 mM Tris HCl (pH 8.0), 50 mM EDTA (pH 8.0), 700 mM NaCl, CTAB (1%), β-mercaptoethanol (0.1%), PVP (0.2%), and SDS (1%)). The samples were incubated at 65°C in a water bath for 60 min and then allowed to cool at room temperature. An equal volume (750 μL) of phenol:chloroform:isoamyl alcohol (25:24:1) was added to each tube, vortexed, and centrifuged at 12,000 rpm for 5 min. The top aqueous phase was transferred to a fresh Eppendorf tube and mixed with an equal volume of chloroform:isoamyl alcohol (24:1) for 5 min. The samples were centrifuged at 12,000 rpm for 5 min. The top aqueous phase was re-transferred to a new Eppendorf tube, and an equal volume of ice-cold isopropanol was added. The tubes were incubated at −20°C for 1 h. The precipitate was collected by centrifugation, and the pellet was washed with 70% ethanol. The supernatant was decanted, and the pellet was dried for 20 min and dissolved in TE buffer. DNA quality was analyzed through agarose gel electrophoresis on 0.8% agarose gel.
Amplification of ITS Region
Polymerase chain reaction (PCR) amplification of the 5.8S rDNA region was carried out using ITS1 (5′- TCCGTAGGTGAACCTGCGG - 3′) and ITS4 (5′-TCCTCCGCTTATTGATATGC-3′) primers, as described in [40]. PCR was performed with a 10 μL reaction mixture containing 1μL of template DNA (50 ng), 5 μL of master mix (Bangalore Genei, Pvt. Ltd., Bangalore, India), 1 μL each of the ITS primers, and 2 μL of nuclease-free water (Fermentas, USA). The reactions were performed in the Eppendorf Gradient S Mastercycler (Eppendorf, Hamburg, Germany). Cycling conditions were 94°C for 3 min, followed by 35 cycles at 94°C for 1 min, 52°C for 1 min, and 72°C for 1 min, and a final extension at 72°C for 10 min with a lid heating option at 104°C. The PCR-amplified products (10 μL) were separated through electrophoresis (Genei Maxi Sub System 03-04, Bangalore Genei, Pvt. Ltd.) on a 1.2% agarose gel using TAE buffer at 80 V constant current for 1 h. The gel was stained with ethidium bromide and visualized using a gel documentation system (UVITEC, Cambridge, UK). Sizes of the PCR products were determined in comparison with the standard 1-kb molecular marker (Bangalore Genei Pvt. Ltd.).
Isolation and Identification of Chaetomium spp.
Isolation of Chaetomium spp.
Chaetomium species were isolated from the rhizosphere soil samples of tomato fields using the soil plate and baiting technique [27]. Small pieces of sterilized paddy straw or filter paper were placed in sterile Petri dishes containing 10 g of rhizosphere soil moistened with sterile distilled water. The plates were incubated at room temperature. Ascomata formed on the straw and top lid of the Petri plates were placed aseptically in the PDA medium and incubated at 28°C ± 2°C. Mycelial growth initiated from the ascomata further cover the Petri plate. The single colony was sub-cultured and used for further studies.
Cultural and Morphological Characters of Chaetomium sp.
The cultural characteristics, viz., colony colour, texture, colour change in medium, and growth rate of Chaetomium spp., were studied [31]. The morphological characters, viz., mycelial appendages, perithecium, ascus, and ascospores, were observed under the microscope.
Testing the Antagonistic Potential of Chaetomium spp. Against F. solani
Antagonistic activity of Chaetomium isolates was tested against F. solani (Fs-1) using dual culture technique [6]. One day before pathogen inoculation, a 5-mm mycelial disc of Chaetomium spp. was placed 10 mm away from the edge of the Petri plates (containing PDA medium) on one side. On the opposite side, a 5-mm mycelial disc of the pathogen was placed similarly. The dual culture plates were incubated for 9 days at 28°C ± 2°C. Three replications were maintained for each treatment. The pathogen and Chaetomium isolates were grown separately in monoculture as the control. The plates were examined periodically, and the expression of antagonism was recorded. The radial growth of the pathogen and antagonist was also measured constantly until the control plates attained full growth (90 mm).
Molecular Identification of Chaetomium spp.
Isolation of Fungal DNA by CTAB Method
The isolated antagonist was identified at the species level by extracting DNA from the suspension cultures of Chaetomium spp. by using the CTAB method [18] as already described.
Amplification of ITS Region in Chaetomium spp.
PCR amplification was performed using ITS1 (5′-TCCGTAGGTGAACCTGCGG-3′) and ITS4 (5′ - TCCTCCGCTTATTGATATGC - 3′) primers [40], to amplify the 5.8S rDNA region. PCR was performed with 10 μL reaction mixture containing 1 μL of template DNA (50 ng), 5 μL of master mix (Bangalore Genei Pvt. Ltd.), 1 μL each of the ITS primers, and 2 μL of nuclease-free water. The reactions were carried out using an Eppendorf Gradient S Mastercycler. Cycling conditions were 94°C for 4 min, followed by 35 cycles at 94°C for 1 min, 52°C for 1 min, and 72°C for 2 min, and a final extension at 72°C for 10 min. The PCR-amplified products (10 μL) were separated through electrophoresis (Genei Maxi Sub System 03-04), as described previously under agarose gel electrophoresis.
Extraction of the Biomolecules from C. globosum
Five hundred milliliters of conical flasks, each containing 300 mL of sterilized Potato Dextrose Broth (PDB), was inoculated with 5-mm mycelial discs of C. globosum (5 in each flask). Three replications along with control were maintained. The flasks were placed in an incubator cum shaker maintained at 25°C and agitated at 120 rpm. One fifty milliliters of culture filtrates was collected from each replication at constant intervals, viz., 5th, 10th, 15th, and 20th day after inoculation under aseptic conditions and filtered through a membrane filter (0.2 μm). The culture filtrates thus collected were checked for their compound production in order to fix the right stages for the collection of secondary metabolites. The collected cell free culture (CFC) filtrates (150 mL) was mixed with the equal volume of ethyl acetate, kept at 150 rpm for 24 h. The ethyl acetate fractions were separated using a separating funnel and were lyophilized at 45°C. Then, the powder was diluted with HPLC grade methanol. The diluted biomolecules of culture filtrate condensate of C. globosum (Chg 2) was subjected to TLC.
Detection of Metabolite Production at Different Interval by Thin Layer Chromatography (TLC)
The diluted biomolecules of culture filtrates of C. globosum (Chg 2) were spotted on to silica gel 60 TLC plates (60 F254, 0.12 mm thick, 5 × 20 cm, Merck, Germany) at the rate of 10 μL/spot. After drying, chromatographs were developed using the solvent systems, viz., chloroform:methanol:glacial acetic acid in the ratio of 75:20:5. The developed TLC plates were air dried overnight to remove the remaining solvents. TLC plates were viewed under UV trans-illuminator at 254 nm. The retention factor (Rf) values of various compounds resolved on TLC plates were calculated using the formula.
Efficacy of Biomolecules against F. solani
The compounds in powder were diluted with HPLC grade methanol and prepared at different concentrations, viz., 0.5, 1.0, 1.5, and 2.0%. The inhibitory effect of the ethyl acetate fraction of the secondary metabolite of C. globosum was evaluated using the agar well diffusion method [35]. After solidification of the sterile PDA medium in Petri plates, 10-mm diameter wells were made on all four sides of each plate using a sterile cork borer; the wells were equidistant and 1 cm of space was left from the periphery. The ethyl acetate fraction (bioactive molecules of culture filtrate) was prepared at 0.5%, 1.0%, 1.5%, and 2.0% concentrations and was poured separately at 100 μL/well by using a micropipette. Actively growing 5-days-old mycelial discs (diameter: 5 mm) of the pathogen were inoculated separately at the centre of each Petri plate and incubated at 28°C ± 2°C for 10 days. The radial growth of the mycelium (mm) and zone of inhibition (mm) were recorded when the mycelial growth in the control reached 90 mm. Based on the observation, percent inhibition over the control was calculated using the formula [39].
Gas Chromatography-Mass Spectrometry (GC-MS) and Fourier Transform Infrared (FTIR) Spectroscopy
Identification of Molecules through GC-MS
The biomolecules of culture filtrate condensate of C. globosum (Chg2) diluted with methanol were subjected to gas chromatography-mass spectrometry (GC-MS) analysis. The column Elite-5MS (100% dimethylpolysiloxane) 30m length × 0.25 mm ID × 0.25 μ particle size equipped with GC Clarus 500 Perkin Elmer and turbo mass–gold-Perkin Elmer detector was used. The carrier gas (helium) flow rate was 1 mL min−1, and split 10:1 and injected volumes were 2 μL. The column temperature was initially maintained at 110°C at the rate of 10°C min−1, followed by an increase of up to 280°C at a rate of 5° C min−1 and a hold time of 9 min. The injector temperature was 250 °C, and this temperature was held constant for 36 min. The electron impact (EI) energy was 70 eV, the Julet line temperature was set at 2000 °C, and the source temperature was set at 200 °C. The EI mass scan (m/z) was recorded in the 45–450 aMU range. The compounds present in the sample were identified using computer searches on the NIST Ver. 2011 MS data library and comparing the spectrum obtained through GC-MS. After GC-MS analysis, based on their result shown in the chromatogram, it was further planned to purchase benzothiazole compound to test the antifungal activity against F. solani.
Effect of Benzothiazole on the Mycelial Growth of F. solani
The volatile compound detected with the highest peak, benzothiazole, was procured from Sigma-Aldrich, Inc., USA (102071596). This product was dissolved in acetonitrile (1%), and serially diluted with acetonitrile to obtain 25, 50, 75, 100, 500, 1000, 2000, 3000, 4000, and 5000 ppm. All these dilutions were tested against F. solani (Fs-1) using the paper disc assay and agar well diffusion assay.
Agar Well Diffusion Assay
The benzothiazole at different concentrations was poured separately @100 μL/well. Actively growing 5-days-old mycelial discs (diameter: 6 mm) of F. solani (Fs-1) was inoculated at the centre of the Petri plate and incubated at 28°C ± 2°C for 8 days. The replica plating technique for each dose was followed with 3 replications. The wells poured with sterile distilled water instead of benzothiazole served as the control. The radial growth of the mycelium (mm) and zone of inhibition (mm) were recorded after 7 days of incubation. Percent inhibition over control was calculated [39].
Paper Disc Assay
For the paper disc assay, the filter paper (Whatman No. 40) was cut into small pieces of size 7 mm and was impregnated with 50 μL of each dilution. The solvents were then allowed to evaporate completely. The paper discs loaded with benzothiazole were placed at the four corners of the Petri plates containing PDA medium. The mycelial disc of F. solani (Fs-1) was placed in the centre of the plates. The filter paper discs impregnated with 50 μL water served as the control. The fungal mycelial inhibition was recorded when there was 100% mycelial growth in the control. Each treatment was replicated three times.
FTIR Analysis for Antimicrobial Compounds of C. globosum
The Fourier transform infrared (FTIR) spectroscopy analysis was performed using Jassco FTIR 6800 at the Department of Agricultural Microbiology, Tamil Nadu Agricultural University (TNAU), Coimbatore, Tamil Nadu, India, to detect the characteristic peaks and the functional groups of antimicrobial compounds produced by C. globosum. The ethyl acetate fraction of the secondary metabolite of C. globosum was prepared at 20,000 ppm concentration and directly encased in the sample holder and spectra from 3782 to 620 cm−1.
Pot Culture Experiment
The commercial culture of T. asperellum was obtained from the culture collection facility available in the Department of Plant Pathology, Tamil Nadu Agricultural University, Coimbatore, Tamil Nadu, India. The pure cultures of T. asperellum were prepared using the single hyphal tip method. From the pure culture, actively growing mycelial discs were transferred to conical flasks containing 150 mL of potato dextrose broth and incubated at room temperature for 15 days. The cell-free culture filtrate was collected after 15 days by following the same method used for C. globosum.
Growth Promotion Activity
Tomato seeds cv. PKM1 were surface sterilized with 1% sodium hypochlorite for 30s, rinsed in sterile distilled water, and aseptically dried for 2 h. The seeds were soaked separately in the cell-free culture filtrate of C. globosum and T. asperellum, bioactive molecules of the culture filtrate condensate (15 days old) of C. globosum (spore- and mycelial-free suspension), carbendazim (0.1%), and sterile distilled water for 2h and allowed to dry overnight in a sterile Petri plate. The treated seeds were placed in a roll towel at a distance of 2 cm from each other. The treated seeds were held in position by placing the presoaked germination paper and gently pressed. The polythene sheet, along with seeds placed on the germination paper was then rolled and incubated in the growth chamber for 15 days. Five replications were maintained for each treatment. The root and shoot lengths of individual seedlings were measured, and the germination percentage of seeds was also calculated. The vigour index was calculated [1].
Effect of Culture Filtrate and Biomolecules of C. globosum on Wilt Incidence
A pot culture experiment was conducted to assess the efficacy of culture filtrate and biomolecules of C. globosum on wilt incidence in tomato (Var. PKM 1). The experiment was laid out in a Randomized Block Design (RBD) with five treatments. The details of the treatment are as follows
Tr. No | Treatment details |
|---|---|
T1 | Culture filtrate of C. globosum (Chg 2) @ 2.0% |
T2 | Bioactive molecules of culture filtrate condensate of C. globosum (Chg 2) @ 2.0% |
T3 | Culture filtrate of T. asperellum @ 2.0% |
T4 | Carbendazim (Chemical control) @ 0.2% |
T5 | Control (water) |
The potting mixture, consisting of laterite soil, sand, and compost (3:1:1), was steam-sterilized in an autoclave at 120 lb pressure for 2 h on alternate days. The sterilized potting mixture was filled into the pots @ 2 kg/pot. The pathogen, F. solani (Fs-1), multiplied in potato dextrose broth was added (106 conidia mL−1) @ 1% to the potting mixture. Fifteen-day-old seedlings were soaked separately in the different treatment solutions for 2 h, and a single seedling was planted per pot. Five replications were maintained for each treatment, and each replication contained 15 plants. The plants were watered regularly, and disease incidence was recorded from 60 days after planting. Wilt incidence was recorded by using the formula, Percent disease incidence = (Number of diseased plants /number of plants observed) × 100. Biometric parameters such as plant height, number of leaves, and number of flowers were also measured 60 days after planting. Relative humidity in the glasshouse was maintained at approximately 75% with a temperature of 30–32°C during the daytime and 26–28°C during the nighttime throughout the experiment.
Statistical Analysis
The data were statistically analyzed using the AGRES software version 92. The percentage values of the disease incidence are arcsine transformed. Data were subjected to analysis of variance (ANOVA) at two significant levels (P<0.05 and P<0.01) and means were compared by least significant difference (LSD) [9].
Results
Isolation and Characterization of Fusarium sp.
The pathogen causing wilt disease was isolated from the naturally infected tomato plants from a farmer’s field (Fig. 1). The isolation yielded fungal growth on PDA medium, which showed a close resemblance to Fusarium sp. The pathogen was purified, sub-cultured at frequent intervals and used for further studies.
The fungus associated with the wilt disease of tomato showed white mycelial growth initially on PDA medium, which changed to creamy white and later to pink. A change in the colour of the medium was also observed. Microscopic structures such as macroconidia, microconidia, and chlamydospores were observed in the 10-day-old culture. Macroconidia were hyaline, sickle-shaped, with 3–4 septations. Microconidium was oval, hyaline, single, or bicelled. Chlamydospores are produced either terminally or intercalary. Based on the morphological evidence, the pathogen was confirmed as Fusarium sp.
Molecular Identification of Fusarium sp.
The purified DNA extracted from Fusarium sp. was subjected to PCR using the universal primers ITS1 and ITS4. The Fusarium isolate produced an amplicon of size 541 bp. The sequence of Fusarium sp. showed 97.88% similarity with Fusarium solani. The sequence was submitted to the NCBI database under accession no. OR122532 (similar species accession nos. MT560338.1 and MN249607.1).
Isolation and Identification of Chaetomium spp.
Nine isolates of Chaetomium spp. were obtained from the soil samples and designated as Chg1–Chg9. Among the 9 isolates, rapid mycelial growth and maximum sporulation was noticed in the isolate Chg2 (Fig. 2). Ascomata with ascospore were formed in all isolates except Chg5 (Fig. 3a and b).
Antagonistic Assay of C. globosum against F. solani
Nine different isolates of Chaetomium spp. were screened for their antagonistic potential against F. solani (Fs-1) in vitro. Among the 9 isolates, 3 were the most effective against F. solani, and the remaining isolates showed different type of interaction with the pathogen (Table 1). Chg2 showed maximum inhibition (49.2%) of the mycelial growth of F. solani, followed by Chg6 (47.4%) and Chg1 (46.3%).
Molecular Identification of Chaetomium spp.
Based on the antagonistic assay results, the three effective isolates, viz., Chg1, Chg2, and Chg6, were subjected to PCR amplification of the 5.8S rDNA region. The amplification yielded a product size of approximately 600 bp. Based on the BLASTN results of the ITS-rDNA sequence, the three isolates were identified as C. globosum (NCBI GenBank accession nos. MN082026 for Chg1, MN069626 for Chg2, and MK791708 for Chg6). The results revealed that the partial sequence of the rDNA region of the three isolates had 100% identity with C. globosum in the GenBank database.
Detection of Metabolite Production by C. globosum at Different Interval
The metabolites were collected and extracted on 5th, 10th, 15th, and 20th days after inoculation and spotted on TLC plates. The results indicated that the compound production was peak on 15th day. Some of the compounds disappeared on 20th day after inoculation. Hence, we have chosen 15th day old culture filtrate for testing against F. solani (Fig. 4).
Efficacy of Crude Secondary Metabolites against F. solani
The ethyl acetate fraction of the culture filtrate condensate of the three potential C. globosum isolates, namely Chg1, Chg2, and Chg6, was collected on 15th day after inoculation and was tested for their antifungal ability against F. solani using agar well diffusion method. The results revealed that the ethyl acetate fraction of Chg2 exhibited the maximum percent reduction in the mycelial growth of the pathogenic fungus (49.5% over the control) at 2.0% concentration (Table 2), followed by Chg6 (46.4% over the control) at a higher concentration. However, 0.5% concentration of Chg1 showed minimum inhibitory activity (38.0%) against F. solani.
Metabolomic Analysis of C. globosum (Chg2) through GC-MS
The presence of nine compounds was revealed by GC-MS analysis (Table 3). Among the nine compounds, benzothiazole, 2-(2-hydroxyethylthio) (7.51%) at 28.94 RT had the highest peak area followed by 9, 12, 15 - octadecatrienoic acid, 2, 3-bis[(trimethylsilyl)oxy]propyl ester, hexadecanoic acid, and 1-(hydroxymethyl) - 1,2 - ethanediyl ester (Fig. 5).
Effect of Benzothiazole Volatile Assay on F. solani
The highly abundant molecule, benzothiazole, was detected at 28.94 RT through GC-MS analysis. To test the hypothesis, that the antifungal nature of C. globosum may be due to the presence of benzothiazole, the synthetic molecule was procured and its efficacy was tested against F. solani through agar well diffusion and paper disc assays. The highest inhibition of 54.4% and 52.3% was recorded at 5000 ppm of benzothiazole, followed by 50.9% and 48.5% at 4000 ppm in agar well diffusion and paper disc assays, respectively. However, lower concentrations of benzothiazole, that is, 25, 50, and 100 ppm, showed no inhibitory activity against F. solani (Fs-1) (Table 4).
FTIR Analysis of Antimicrobial Compounds of C. globosum (Chg2)
The FTIR analysis of the ethyl acetate fraction of C. globosum (Chg2) revealed the distribution of functional groups of active compounds within the fraction. The spectrum indicated that the leading bands were observed in the regions of 620, 1020.16, 1113.669, 1415.49, 1444.42, 1667.16, 1951.61, 2526.29, 2830.03, 2941.88, 3312.14, 3693.98, and 3782.69 cm−1. The spectra indicated the presence of alcohol, secondary amine, aliphatic primary amine, carboxylic acid, allene, conjugated ketone, imine/oxime, sulphate, and halo compound groups with a weak to strong range of intensity. C. globosum (Chg2) produced active compounds of functional groups O-H, N-H, C-N, C=O, S=O, C-I, C=C=C, and N-H (Table 5 and Fig. 6).
Stimulation of Plant Growth and Management of Fusarium Wilt of Tomato
The potential of the culture filtrate and biomolecule composite of Chg2 to control the wilt disease of tomato caused by F. solani (Fs-1) was tested under glasshouse conditions. For comparisons with standard treatments, carbendazim (a fungicide) and T. asperellum (a bioagent) were included in the roll towel and pot culture experiments (Tables 6 and 7). The results obtained on 60 days after planting are presented in Table 7. In the roll towel method, significantly superior root and shoot lengths were recorded in the plants treated with both the culture filtrate and biomolecules of C. globosum (Table 6). In the pot culture experiment, disease incidence was found to be at par, inter alia, excluding the water control. The seedlings dipped in biomolecules of C. globosum and carbendazim showed a minimum disease incidence (20.0%) compared with seedlings subjected to other treatments (Fig. 7). The disease incidence in the seedlings treated with all the four treatments, viz., biomolecules of C. globosum, carbendazim, culture filtrate of C. globosum, and culture filtrate of T. asperellum, were found to be on par. However, seedlings treated with C. globosum culture filtrate outperformed biomolecule and carbendazim treated plants in plant growth parameters such as number of leaves (39.6), plant height (37.6 cm), and number of flowers (5.4). This was followed by the treatment of seedlings with the culture filtrate of T. asperellum. Besides, the seedlings treated with the culture filtrate of C. globosum had the highest plant height of 37.6 cm and the maximum number of leaves and flowers (39.6 and 5.4, respectively), followed by those treated with the biomolecules of C. globosum and culture filtrate of T. asperellum.
Discussion
Discerning the mode of interaction that inhibits the growth of phytopathogens is the prima facie for demonstrating the effectiveness of biocontrol agents [15]. Chaetomium spp. have been used to control rice blast, corn leaf spot, potato late blight, potato black scurf, tomato Fusarium wilt, and citrus and strawberry root diseases [4, 27, 30]. The control of Fusarium wilt by antagonistic microbes represents an alternative and widely accepted strategy in disease management [5]. Inhibition of phytopathogens by antagonistic microbes entails various methods, such as competition for available nutrients, space, parasitism, destruction of fungal cell walls by hydrolytic enzymes, toxins, and inhibition by secreted diffusible compounds [26, 32, 33, 36, 41]. In the present inquest, the rationale for the efficacy of C. globosum on F. solani was deciphered by selecting the potential isolates of C. globosum (Chg1, Chg2, and Chg6) by preliminary in vitro screening and testing the antifungal efficacy of their culture filtrate condensates against the test pathogen. The culture filtrate condensate of Chg2 successfully inhibited the growth of the test pathogen and enhanced plant growth [8].
The secondary metabolites of C. globosum, viz., chaetoglobosin, chaetoviridin A, musanahol, and chaetomin, are known to possess antifungal activity against Bipolaris sorokiniana, Macrophomina phaseolina, R. solani, P. ultimum, and V. dahliae [7, 13, 4, 19, 22, 23, 43]. Secondary metabolites of Chaetomium cupreum also possess antifungal activity against F. solani [33, 34, 42]. Diketopiperazines, diterpenoids, and xanthoquinodines extracted from Chaetomium spp. were found to be effective against Phytophthora sp. and Colletotrichum gloeosporioides [12, 13].
Benzothiazoles contain thiazole-bearing heterocycles and possess antifungal and antibacterial properties [37]. In a separate study, 11 benzothiazole derivatives were evaluated for their antifungal and antibacterial activities. Among these derivatives, 6 derivatives (7b, 7e, 7f, 7g, 7h, and 7j) manifested antifungal activity against Aspergillus flavus, A. fumigatus, Penicillium marneffei, and Mucor sp. under in vitro conditions [17]. 4H-Pyrimido [2,1-b] benzothiazole, a novel compound and derivative of curcumin, was evaluated for its antibacterial activity against Staphylococcus aureus, Pseudomonas aeruginosa, Salmonella typhi, Escherichia coli, Bacillus cereus, and Providencia rettgeri and antifungal activity against A. niger, A. fumigatus, and A. flavus [37]. Similarly, benzothiazole derivatives (5h and 5a) inherently inhibited the mycelial growth of F. solani and Botrytis cinerea [16]. In this study, benzothiazole successfully inhibited the growth of the test pathogen at 5000 ppm. FTIR analysis of culture filtrate condensate of Chg2 revealed the presence of functional groups O-H, N-H, C- N, C=O, S=O, C-I, C=C=C, and N-H (Table 5). Thus, the inhibition of the growth of the test pathogen may be either by benzothiazole alone or its combination with a secondary amine, aliphatic primary amine, carboxylic acid, allene, conjugated ketone, imine/oxime sulphate, or halo compound groups in C. globosum (Chg2).
Testing the in vivo efficacy of the culture filtrate condensate and biomolecule composite of Chg2 showed the superiority in root as well as shoot lengths. Minimum disease incidence was recorded in the seedlings dipped in biomolecules of C. globosum and carbendazim. The present findings were similar to earlier reports [3, 4] who recorded the antifungal nature of biomolecules obtained from C. globosum in decreasing the growth of phytopathogenic fungi, viz., B. sorokiniana, P. ultimum, R. solani, and M. phaseolina [38].
Conclusion
Chaetomium globosum is an effective bioagent for the management of wilt disease, with the same effect as the fungicide carbendazim. The current study also shows that, C. globosum with, crude antifungal biomolecules and volatile compounds like benzothiazole inhibit Fusarium solani. Further studies are warranted to investigate the potential of biomolecules in plant growth promotion and management of phytopathogens thus providing a way for sustainable agriculture.
Data Availability
Not applicable.
References
Abdul Baki, A. A., & Anderson, J. D. (1973). Vigour determination in soybean seed by multiple criteria. Crop Science, 13, 630–633.
Aggarwal, R., Tiwari, A. K., Srivastava, K. D., & Singh, D. V. (2004). Role of antibiosis in the biological control of spot blotch (Cochliobolus sativus) of wheat by Chaetomium globosum. Mycopathologia, 157, 369–377.
Arunkumar, K., Parthasarathy, S., Harish, S., Rajendran, L., & Raguchander, T. (2022). Evaluating an isotonic aqueous formulation of Chaetomium globosum Kunze for the management of potato black scurf disease caused by Rhizoctonia solani Kuhn in India. Journal of Plant Pathology, 104, 203.
Biswas, S. K., Aggarwal, R., Srivastava, K. D., Gupta, S., & Dureja, P. (2012). Characterization of antifungal metabolites of Chaetomium globosum Kunze and their antagonism against fungal plant pathogens. Journal of Biological Control, 26(1), 70–74.
Compant, S., Clement, C., & Sessitsch, A. (2010). Plant growth-promoting bacteria in the rhizo-and endosphere of plants: their role, colonization, mechanisms involved and prospects for utilization. Soil Biology and Biochemistry, 42, 669–678.
Dennis, D., & Webster, J. (1971). Antagonistic properties of species – groups of Trichoderma. II. Production of volatile antibiotics. Transactions of the British Mycological Society, 57(1), 41–48.
Di Pietro, A., Gut–Rella, M., Pachlatke, J. P. and Schwin, F. J. (1992). Role of antibiosis produced by Chaetomium globosum in biocontrol of Pythium ultimum, a causal agent of damping off. Phytopathology 82, 131–135.
Elshahawy, I. E., & Khatta, A. A. (2022). Endophyte Chaetomium globosum improves the growth of maize plants and induces their resistance to late wilt disease. Journal of Plant Diseases and Protection, 129, 1125–1144.
Gomez, K. A., & Gomez, A. A. (1984). Statistical procedure for Agricultural Research (p. 680p). John Wiley and Sons.
Guimaraes, J. B., Pereira, P., Chambel, L., & Tenreiro, R. (2011). Assessment of filamentous fungal diversity using classic and molecular approaches: Case study - Mediterranean ecosystem. Fungal Ecology, 4(5), 309–321.
Harish, S. (2022). Bio - prospecting of endospore – based formulation of Bacillus sp. BST18 possessing antimicrobial genes for the management of soil borne diseases of tomato. Current Microbiology, 79, 380.
Kanokmedhakul, S., Kanokmedhakul, K., Phonkerd, N., Soytong, K., Kongsaree, P., & Suksamrarn, A. (2002). Antimycobacterial anthraquinone-chromanone compound and diketopiperazine alkaloid from the fungus Chaetomium globosum KMITL-N0802. Planta Medica, 68, 834–836.
Kanokmedhakul, S., Kanokmedhakul, K., Phonkerd, N., Thohinung, S., Moosophon, P., Lekphrom, R., Buayairaksa, M., Soytong, K., & Kongsaeree, P. (2007). Bioactive compounds from fungi to control human and plant pathogens. Chiang Mai University, Thailand.
Kirk, P. M., Cannon, P. F., Minter, D. W., & Stalpers, J. A. (2008). Dictionary of the Fungi (10th ed.). CAB International.
Larkin, R. P., Hopkins, D. L., & Martin, F. N. (1996). Suppression of Fusarium wilt of watermelon by nonpathogenic Fusarium oxysporum and other microorganisms recovered from a disease suppressive soil. Phytopathology, 86, 812–819.
Luo, B., Li, D., Zhang, A. L., & Gao, J. M. (2018). Synthesis, antifungal activities and molecular docking studies of benzoxazole and benzothiazole derivatives. Molecules, 23, 1–16.
Maddila, S., Gorle, S., Seshadri, N., Lavanya, P., & Jonnalagadda, S. B. (2016). Synthesis, antibacterial and antifungal activity of novel benzothiazole pyrimidine derivatives. Arabian Journal of Chemistry, 9(5), 681–687.
Martins, A. (2004). Micorriza caocontrolada de Castanea sativa Mill.:Aspectosfisiologicos da micorrizacao in vitro. Dissertacao de doutoramentoem Biologia/ Biotecnologia Information. T’ Department of Microbiology, Silpakorn University.
Marwah, R. G., Fatope, M. O., Deadman, M. L., Al-Maqbali, Y. M., & Husband, J. (2007). Musanahol: A new aureonitol-related metabolite from a Chaetomium sp. Tetrahedron, 63, 8174–8180.
McGovern, R. J. (2015). Management of tomato diseases caused by Fusarium oxysporum. Crop Protection, 73, 78–92.
Osuide, M. I., Aluya, E. I., & Emoghene, A. O. (2002). Control of Fusarium wilt of tomato (Lycopersicon esculentum Mill) by Trichoderma species. Acta phytopathologica et Entomologica Hungarica, 37(1-3), 47–55.
Park, J. H., Choi, G. J., Jang, K. S., Lim, H. K., Kim, H. T., Cho, K. Y., & Kim, J. C. (2005). Antifungal activity against plant pathogenic fungi of chaetoviridins isolated from Chaetomium globosum. FEMS Microbiology Letters, 252, 309–313.
Rajendran, L., Durgadevi, D., Kavitha, R., Divya, S., Ganeshan, K., Vetrivelkalai, P. M., Karthikeyan, G., & Raguchander, T. (2023). Characterization of chaetoglobosin producing Chaetomium globosum for the management of Fusarium - Meloidogyne wilt complex in tomato. Journal of Applied Microbiology, 134(2), 1–15.
Rangaswami, G. (1972). Diseases of crop plants in India (p. 520). Ltd., New Delhi.p.
Refai, M., Hassan, A., & Mamed, M. (2015). Monograph on the genus Fusarium, 275. https://doi.org/10.13140/RG.2.1.3104.2728
Romero, D., de Vicente, A., Rakotoaly, R. V., Dufour, S. E., Veening, J. W., Arrebola, E., Cazorla, F. M., Kuipers, O. P., Paquot, M., & Perez-Garcia, A. (2007). The iturin and fengycin families of lipopeptides are key factors in antagonism of Bacillus subtilis toward Podosphaera fusca. Molecular Plant-Microbe Interactions, 20, 430–440.
Shanthiyaa, V., Saravanakumar, D., Rajendran, L., Karthikeyan, G., Prabakar, K., & Raguchander, T. (2013). Use of Chaetomium globosum for biocontrol of potato late blight disease. Crop Protection, 52, 33–38.
Sibounnavong, P., Charoenporn, C., Kanokmedhakul, S., & Soytong, K. (2011). Antifungal metabolites from antagonistic fungi used to control tomato wilt fungus Fusarium oxysporum f. sp. lycopersici. African Journal of Biotechnology, 10(85), 19714–19722.
Singh, V. K., Singh, H. B., & Upadhyay, R. S. (2017). Role of fusaric acid in the development of Fusarium wilt symptoms in tomato: physiological, biochemical and proteomic perspectives. Plant Physiology and Biochemistry, 118, 320–332.
Soytong, K. (1989). Antagonism of Chaetomium cupreum to Pyricularia oryzae: A case study to biocontrol of a rice blast disease. Thai Phytopathology, 9, 28–33.
Soytong, K. (1990). A taxonomic study of Chaetomium spp. in Thailand. Abstracts, 4th International Mycological Congress, Regensburg, Germany, August 28 –September 3.
Soytong, K. (1992a). Antagonism of Chaetomium cupreum to Pyricularia oryzae. Journal of Plant Protection in the Tropics, 9, 17–24.
Soytong, K. (1992b). Biological control of tomato wilt caused by Fusarium oxysporum f. sp. lycopersici using Chaetomium cupreum. KASETSART JOURNAL (NATURAL SCIENCES), 26, 310–313.
Soytong, K., Kanokmedhakul, S., Kukongviriyapa, V., & Isoba, M. (2001). Application of Chaetomium Ketomium® as a new broad spectrum biological fungicide for plant disease control: A review article. Fungal Diversity, 7, 1–15.
Stoke, J. E., & Ridgway, G. L. (1980). Clinical Bacteriology. Edward Arnold Ltd..
Taechowisan, J. N., Chuaychot, S., Chanaphat, A., & Wanbanjob and Tantiwachwutikul, Z. P. (2009). Antagonistic effect of Streptomyces sp. SRM1 on Colletotrichum musae. Biotechnology, 8, 86–92.
Tomi, I. H. R., Tomma, J. H., Daraji, A., & Al-Dujaili, A. (2015). Synthesis, characterization and comparative study the microbial activity of some heterocyclic compounds containing oxazole and benzothiazole moieties. Journal of Saudi Chemical Society, 19(4), 392–398.
Tomilova, O. G., & Shternshis, M. V. (2006). The effect of a preparation from Chaetomium fungi on the growth of phytopathogenic fungi. Applied Biochemistry and Microbiology, 42, 67–71.
Vincent, J. M. (1927). Distortion of fungal hyphae in the presence of certain inhibitors. Nature, 159, 850.
White, T. J., Bruns, T., Lee, S., & Taylor, J. (1990). Amplification and direct sequencing of fungal ribosomal RNA genes for phylogenetics. In M. A. Innis, D. H. Gelfand, J. J. Sninsky, & T. J. White (Eds.), PCR protocols, a guide to methods and applications (pp. 315–322). Academic press.
Yang, S. X., Gao, J. M., Zhang, Q., & Laatsch, H. (2011). Toxic polyketides produced by Fusarium sp, an endophytic fungus isolated from Melia azedarach. Bioorganic & Medicinal Chemistry Letters, 21(6), 1887–1889.
Zhang, H. Y., & Yang, Q. (2007). Expressed sequence tags-based identification of genes in the biocontrol agent Chaetomium cupreum. Applied microbiology and biotechnology, 74, 650–658.
Zhang, Y., Zhu, H., Ye, Y., & Tang, C. (2021). Antifungal activity of chaetoviridin A from Chaetomium globosum CEF-082 metabolites against Verticillium dahliae in cotton. Molecular Plant-Microbe Interactions, 34(7), 758–769.
Acknowledgments
The authors thank the Department of Plant Pathology, Centre for Plant Protection Studies, Tamil Nadu Agricultural University, Coimbatore, for providing the laboratory support to conduct this study.
Funding
The research work was supported by the Women Scientist Scheme (SR/WOS-A/LS-284/2017) (E28ACH), Department of Science and Technology, Government of India.
Author information
Authors and Affiliations
Contributions
All the authors contributed to study conception, experimentation, writing, review, and editing.
Corresponding author
Ethics declarations
Ethical Approval
No human and/or animal participants were involved in this study.
Consent to Participate
Not applicable.
Consent for Publication
Not applicable.
Competing Interests
The authors declare no competing interests.
Additional information
Publisher’s Note
Springer Nature remains neutral with regard to jurisdictional claims in published maps and institutional affiliations.
Rights and permissions
Springer Nature or its licensor (e.g. a society or other partner) holds exclusive rights to this article under a publishing agreement with the author(s) or other rightsholder(s); author self-archiving of the accepted manuscript version of this article is solely governed by the terms of such publishing agreement and applicable law.
About this article
Cite this article
Sangeetha, C., Kiran Kumar, N., Krishnamoorthy, A.S. et al. Biomolecules from Chaetomium globosum Possessing Antimicrobial Compounds Potentially Inhibits Fusarium Wilt of Tomato. Appl Biochem Biotechnol 196, 2196–2218 (2024). https://doi.org/10.1007/s12010-023-04620-9
Accepted:
Published:
Issue Date:
DOI: https://doi.org/10.1007/s12010-023-04620-9